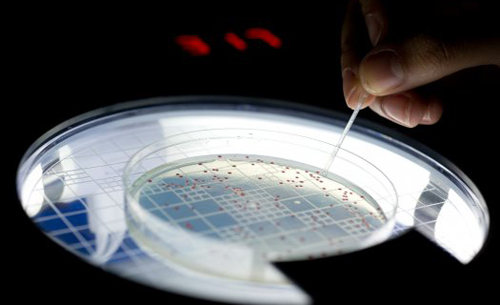

上海交通大学微生物代谢国家重点实验室林双君研究小组通过对链黑菌素生物合成基因簇进行基因解析,阐明了链黑菌素复杂的生物合成途径。由此得到的链黑菌素类似物不仅抗癌活性高很多,其毒性上也比原始链黑菌素降低了约5倍。该研究成果近日发表在国际权威学术期刊《美国化学会会志》上。
链黑菌素是由一株绒毛链霉菌所产生的抗肿瘤抗生素,具广谱抗肿瘤活性。但在上世纪七八十年代进行二期临床实验时,因其毒性过强而被迫终止。
基因组测序技术为生物合成机制的研究提供了更多信息。林双君研究小组首先克隆了链黑菌素潜在的抗生素基因簇,定位出链黑菌素的生物合成的48个独立基因编码,再通过微生物遗传学、化学及生物化学技术和手段,获得了其中17个基因的突变菌株,从中分离鉴定了12个与链黑菌素生物合成相关化合物的化学结构,提出了链黑菌素生物合成途径的模型。
在这一过程中,还揭示了多个新颖或关键的酶催化反应的分子生物学机制。该项研究为抗生素药物新颖酶催化反应基因的挖掘,并利用合成生物学等前沿生物技术创造新的结构衍生物奠定了基础。林双君称,这是首次在基因水平实现链黑菌素的生物合成途径的解析。
课题组通过基因工程技术获得的一个链黑菌素类似物,在抗癌活性上比目前临床使用的抗癌药物高很多。这个类似物在临床应用方面,对治疗淋巴瘤、白血病、鼻咽癌等疾病将有更大的优势。林双君表示,只要将产量提高到可规模化生产,就可将链黑菌素或类似物转化为一个新型的抗癌药物,不仅有望降低药价,而且减少化疗时产生的毒副作用。
